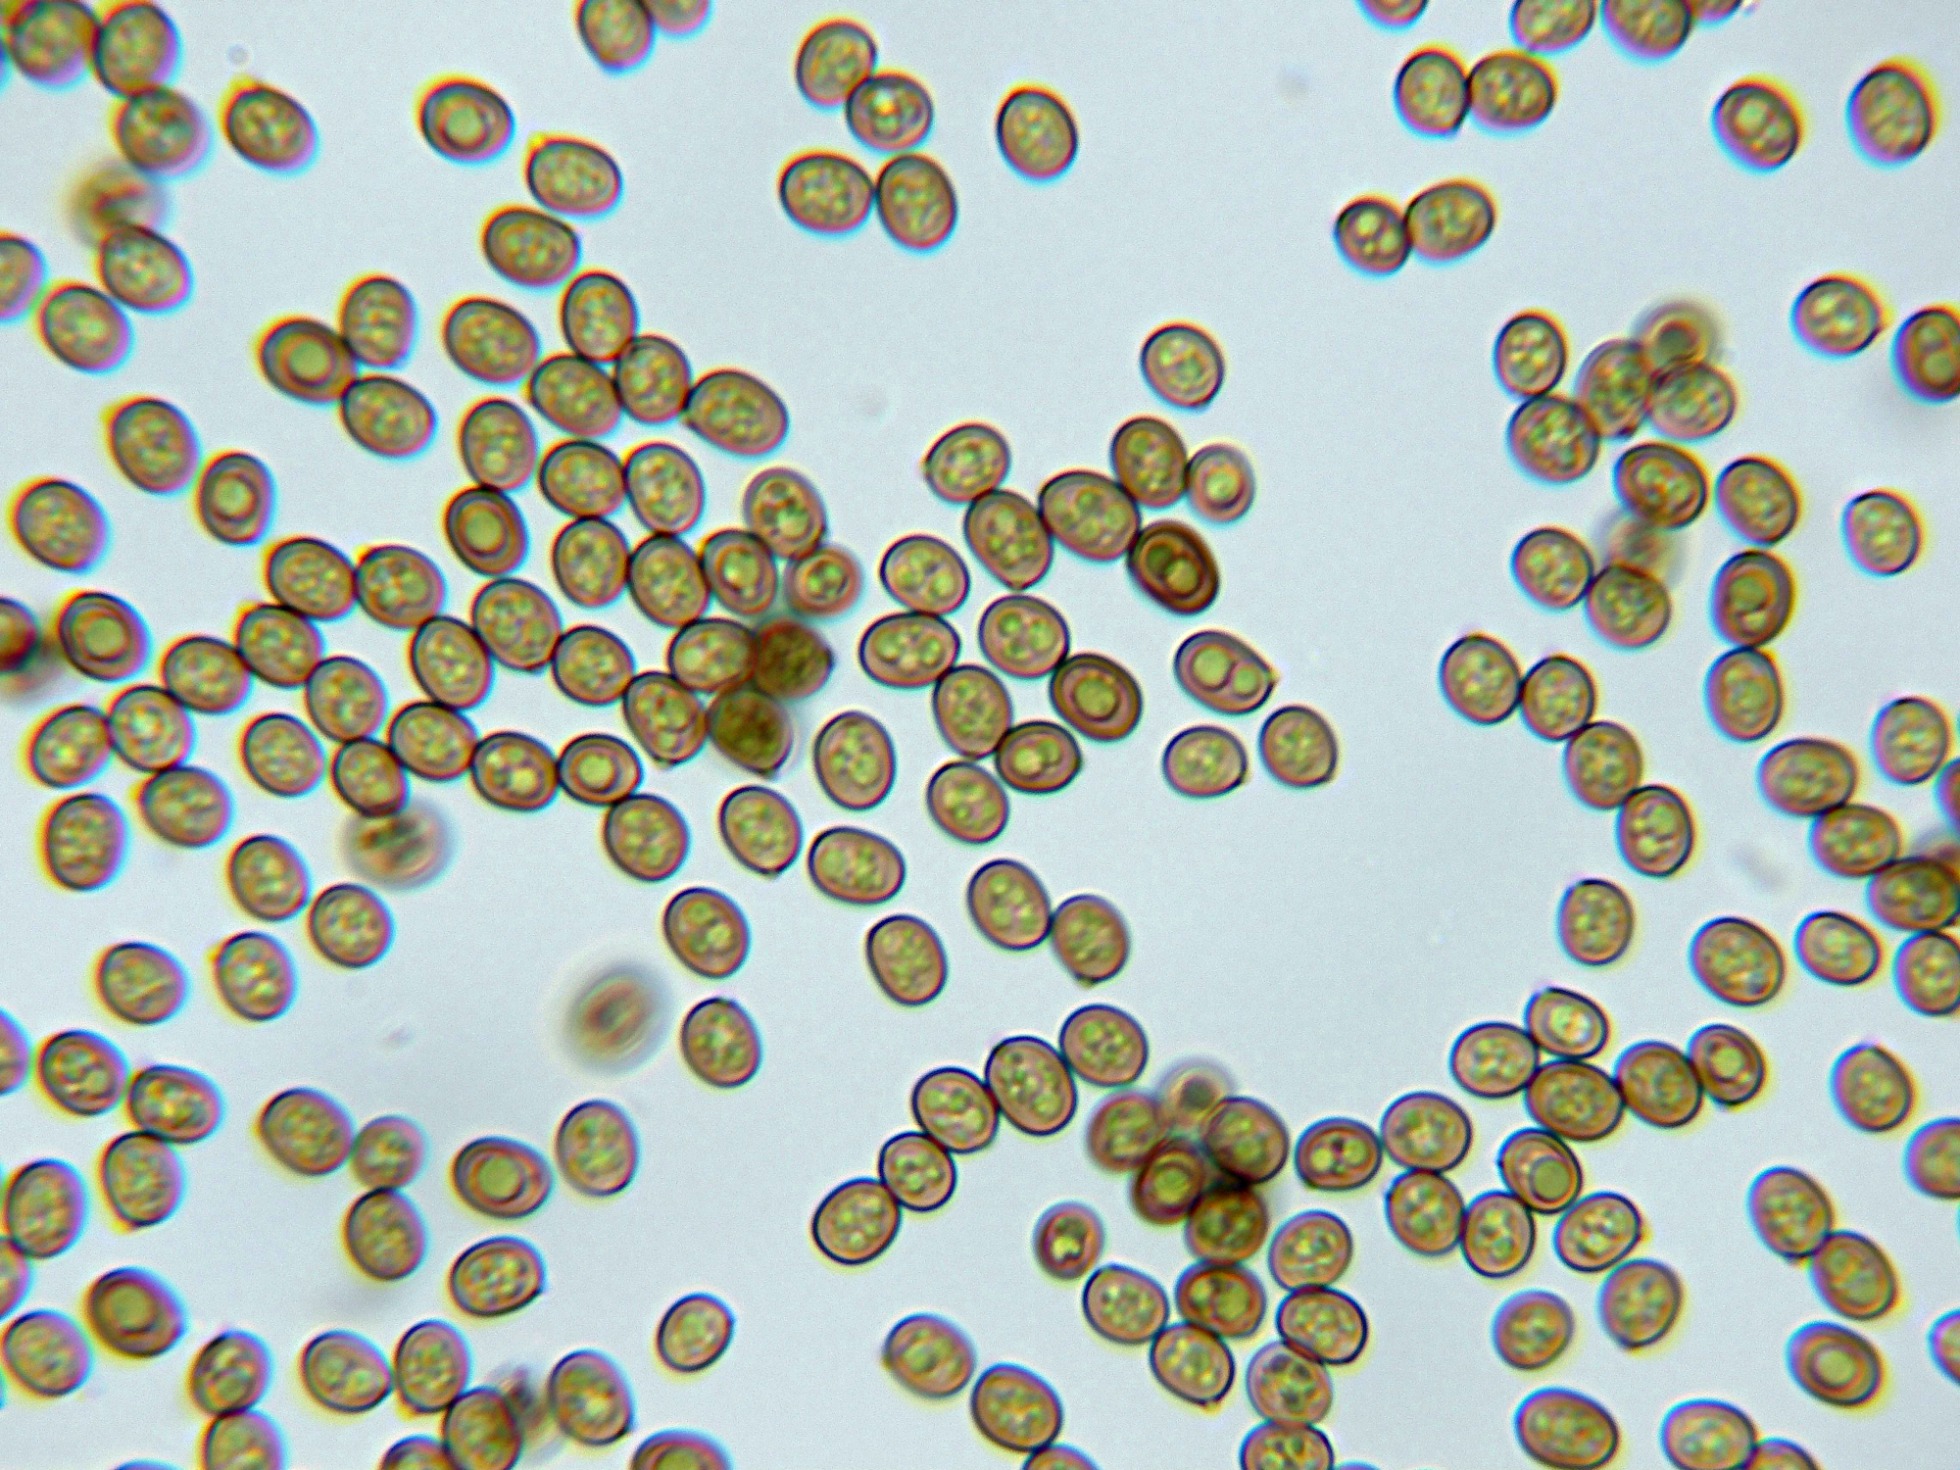

- Foro
- Foros sobre Micología de fungipedia
- Microscopía
- Agaricus bisporus (J.E. Lange) Imbach. Microscopía
 Agaricus bisporus (J.E. Lange) Imbach. Microscopía
Agaricus bisporus (J.E. Lange) Imbach. Microscopía
- Josep Torres
-
 Autor del tema
Autor del tema
- Fuera de línea
- Moderador
-

Menos
Más
- Mensajes: 8746
- Gracias recibidas: 8379
3 años 3 meses antes #108456
por Josep Torres
Hola a tod@s.
Un corro de champis de ayer domingo brotando entre la hierba de un Espacio Natural de mi ciudad.
Agradecer a Luís Alberto Parra, su opinión para la correcta identificación de la especie.
Agaricus bisporus (J.E. Lange) Imbach
Ejemplares brotando de manera dispersa, con olor fúngico suave y carne que enrojece muy levemente a unos tonos marrón rojizos pálidos.
Suprapellis filamentosa compuesta por hifas poco pigmentadas y sin fíbulas.
La suprapellis en agua:
Queilocistidios abundantes, cilíndricos, claviformes y ensanchados en el ápice.
Todos los basidios observados monospóricos o bispóricos.
Esporas elipsoidales, de pared gruesa, con apícula y contenido granuloso en su interior.
Las esporas con unas medidas en agua de:
(5.8) 6.3 - 7.3 (8.5) × (4.8) 4.9 - 5.7 (6.5) µm
Q = (1.2) 1.22 - 1.3 (1.4) ; N = 40
Me = 6.8 × 5.3 µm ; Qe = 1.3
Saludos a tod@s.
Un corro de champis de ayer domingo brotando entre la hierba de un Espacio Natural de mi ciudad.
Agradecer a Luís Alberto Parra, su opinión para la correcta identificación de la especie.
Agaricus bisporus (J.E. Lange) Imbach
Ejemplares brotando de manera dispersa, con olor fúngico suave y carne que enrojece muy levemente a unos tonos marrón rojizos pálidos.
Suprapellis filamentosa compuesta por hifas poco pigmentadas y sin fíbulas.
La suprapellis en agua:
Queilocistidios abundantes, cilíndricos, claviformes y ensanchados en el ápice.
Todos los basidios observados monospóricos o bispóricos.
Esporas elipsoidales, de pared gruesa, con apícula y contenido granuloso en su interior.
Las esporas con unas medidas en agua de:
(5.8) 6.3 - 7.3 (8.5) × (4.8) 4.9 - 5.7 (6.5) µm
Q = (1.2) 1.22 - 1.3 (1.4) ; N = 40
Me = 6.8 × 5.3 µm ; Qe = 1.3
Saludos a tod@s.
Adjuntos:
El siguiente usuario dijo gracias: Juan Andrés Román, Juan
Por favor, Identificarse para unirse a la conversación.
- Juan
-

- Fuera de línea
- Moderador
-

Menos
Más
- Mensajes: 553
- Gracias recibidas: 608
3 años 3 meses antes #108458
por Juan
Respuesta de Juan sobre el tema Agaricus bisporus (J.E. Lange) Imbach. Microscopía
Muy bonitos agaricus Josep gracias por compartir :3
El siguiente usuario dijo gracias: Josep Torres
Por favor, Identificarse para unirse a la conversación.
- Javi Calvo
-

- Fuera de línea
- Spammer
-

Menos
Más
- Mensajes: 7009
- Gracias recibidas: 2955
3 años 3 meses antes #108460
por Javi Calvo
Respuesta de Javi Calvo sobre el tema Agaricus bisporus (J.E. Lange) Imbach. Microscopía
Buen cromo, no se ve todos los días la versión silvestre de esta especie típica de cultivo
El siguiente usuario dijo gracias: Josep Torres, Juan
Por favor, Identificarse para unirse a la conversación.
- Josep Torres
-
 Autor del tema
Autor del tema
- Fuera de línea
- Moderador
-

Menos
Más
- Mensajes: 8746
- Gracias recibidas: 8379
3 años 3 meses antes #108467
por Josep Torres
Respuesta de Josep Torres sobre el tema Agaricus bisporus (J.E. Lange) Imbach. Microscopía
Muchas gracias a los dos, para Javi a este si lo tuviera que ir a buscar habría ido al lineal del Carrefour, al lado de las lechugas, no sabía tan siquiera que podría aparecer en un espacio natural, fueron las dudas que me surgieron al tomar las fotos ya que por el prominente anillo y el pie no me parecía el típico Agaricus campestris, entonces fue cuando pedí consejo a los compañeros de "La Usonera", a los 5 minutos Luís Alberto ya me la había identificado, y la microscopía no hizo más que confirmar la especie.
Un abrazo a los dos
Un abrazo a los dos
El siguiente usuario dijo gracias: Juan
Por favor, Identificarse para unirse a la conversación.
- Fernando Sanz
-

- Fuera de línea
- Navegador Experto
-

Menos
Más
- Mensajes: 159
- Gracias recibidas: 158
3 años 3 meses antes #108475
por Fernando Sanz
Respuesta de Fernando Sanz sobre el tema Agaricus bisporus (J.E. Lange) Imbach. Microscopía
Hola Josep. Si hubieras realizado un corte, es muy posible que hubieras dado con Agaricus bisporus, al observar el anillo complejo que tiene, así como el enrojecimiento en toda su carne. Respecto a su localización no resulta tan difícil de encontrar si se tiene en cuenta que sale en zonas ruderales, escombreras, incluso en los fardos de paja viejos, donde adquieren unas dimensiones exageradas. Saludos
El siguiente usuario dijo gracias: Josep Torres, Juan
Por favor, Identificarse para unirse a la conversación.
- Josep Torres
-
 Autor del tema
Autor del tema
- Fuera de línea
- Moderador
-

Menos
Más
- Mensajes: 8746
- Gracias recibidas: 8379
3 años 3 meses antes #108479
por Josep Torres
Respuesta de Josep Torres sobre el tema Agaricus bisporus (J.E. Lange) Imbach. Microscopía
Gracias Fernando, lo del corte ya me lo dijo Luís Alberto al ver mis imágenes, y por supuesto lo tendré muy en cuenta para la próxima ocasión, es que llevaba ya mucho tiempo sin fijarme en los Agaricus, y no soy ni mucho menos experto en ellos, lo único que tenía claro en el momento de la recogida es que por el aspecto del anillo y el pie no se trataba del Agaricus campestris.
De nuevo muchas gracias por tu información.
Saludos
De nuevo muchas gracias por tu información.
Saludos
El siguiente usuario dijo gracias: Juan
Por favor, Identificarse para unirse a la conversación.
- Foro
- Foros sobre Micología de fungipedia
- Microscopía
- Agaricus bisporus (J.E. Lange) Imbach. Microscopía
Tiempo de carga de la página: 0.174 segundos

Foro de micología